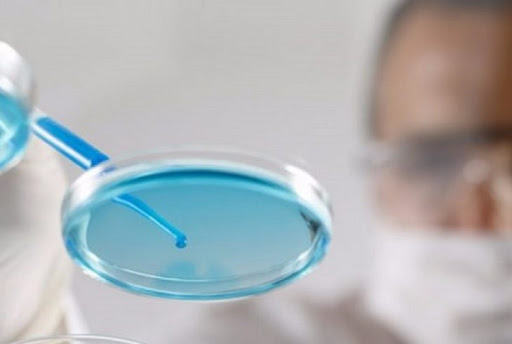

Pixium Vision and Second Sight Medical Products announce business combination, creating a global leader in the sight restoration market
Pixium Vision, a bioelectronics company that develops innovative bionic vision systems to enable patients who…
Ben (Reactive)06/01/2021